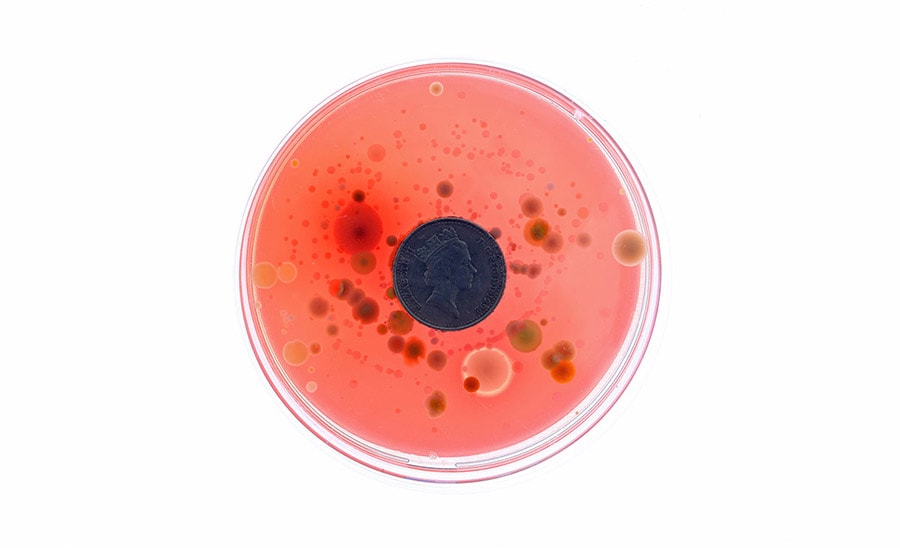
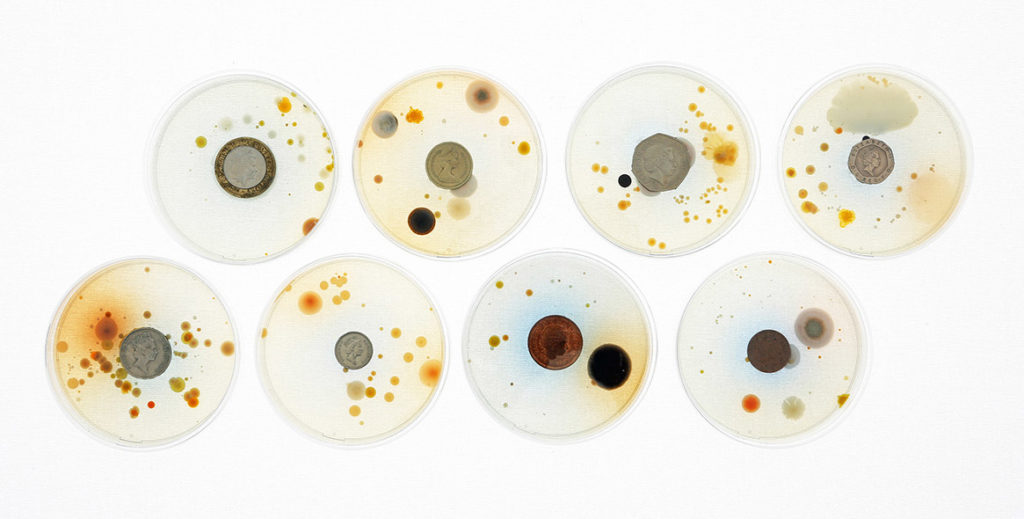
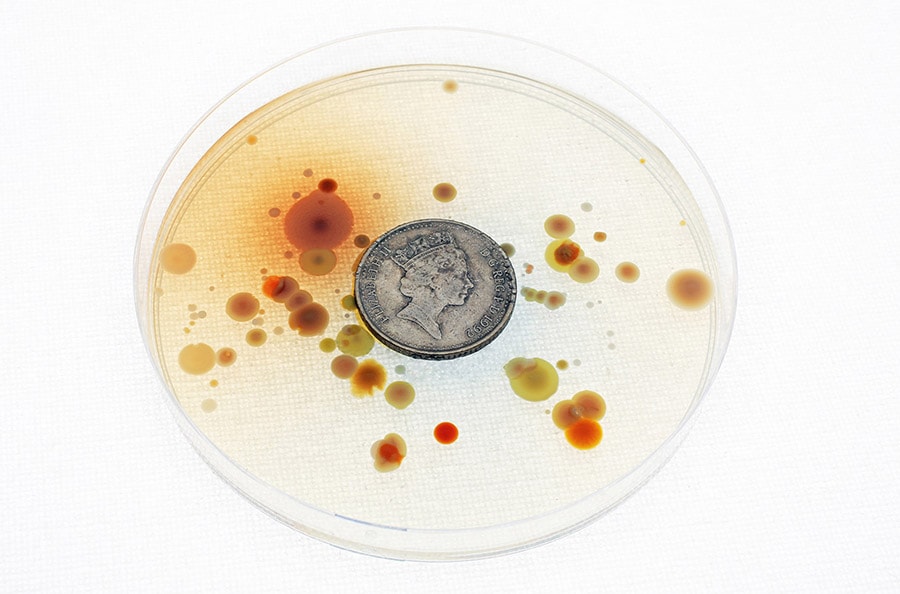
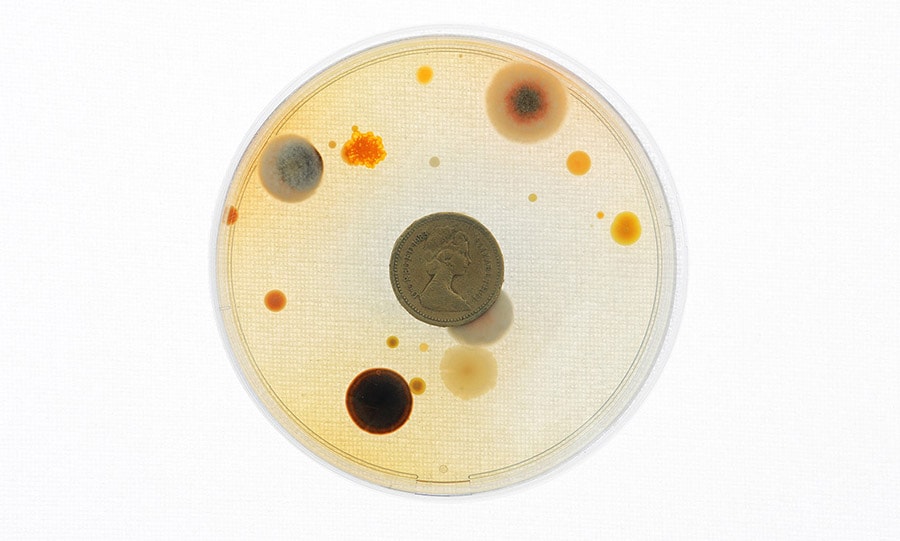

|
|
 [Image: From The Hunt For Red October, via Quora]. [Image: From The Hunt For Red October, via Quora].
There’s a throwaway line in The Hunt For Red October where a submarine navigator jokes, “Give me a stopwatch and a map, and I’ll fly the Alps in a plane with no windows.” I was reminded of that comment by reports of a new atomic clock that will allegedly enable “ futuristic navigation schemes”: “Every single spacecraft exploring deep space today relies on navigation that’s performed back here at Earth,” said [Jill] Seubert, who’s based at NASA’s Jet Propulsion Laboratory in Pasadena, Calif. Earth-based antennas send signals to spacecraft, which the spacecraft echo back. By measuring a signal’s round-trip time within a billionth of a second, ground-based atomic clocks in the Deep Space Network help pinpoint the spacecraft’s location.
With the new Deep Space Atomic Clock, “we can transition to what we call one-way tracking,” Seubert said. A spaceship would use such a clock onboard to measure the time it takes for a tracking signal to arrive from Earth, without having to send that signal back for measurement with ground-based atomic clocks. That would allow a spacecraft to judge its own trajectory. One might say that the ship is navigating time as much as it is traveling through space—steering through the time between things rather than simply following the lines that connect one celestial object to another.
The general problem of ship orientation and navigation in deep space is a fascinating one, and it has led to ideas like using “ dead stars” as fixed directional beacons, a kind of thanato-stellar GPS. This is “the long-sought technology known as pulsar navigation,” Nature reported last year. “For decades, aerospace engineers have dreamed of using these consistently repeating signals for navigation, just as they use the regular ticking of atomic clocks on satellites for GPS.” You head toward something that’s only consistent because it’s dead.
There is something really interesting here, where human navigators and their far-flung machines are confronted with a landscape so vast it is all but devoid of local landmarks. Imagine the cognitive skills necessary for early humans to wander forth, on foot, across colossal and empty steppes, long before modern navigational tools, or picture autonomous, near-frozen hard-drives falling endlessly outward toward stars they might never reach: these scenarios lend themselves to metaphor just as much as they present real-world cartographic problems masked as an encounter with landscapes impossibly huge.
A landscape so big it becomes time, and only a clock can conquer it; or a space so empty, its only fixed points are long dead.
I’m finally back from several weeks of travel and wanted to post some recent news I was particularly thrilled about: my book, A Burglar’s Guide to the City, is being developed for television by CBS Studios. From Variety: The drama, which landed a put pilot commitment, hails from writer Paul Grellong (“Scorpion,” “Revolution”) and exec producers Alex Kurtzman, Heather Kadin, Danielle Woodrow, and Justin Lin, who is attached to direct the pilot.
“A Burglar’s Guide to the City” follows a team of modern-day Robin Hoods, led by a brilliant architect with a troubled past, that uses their unique skills to gain access to any stronghold in order to steal from rich criminals and give to those that have been wronged by a corrupt system.
The potential series is based on Geoff Manaugh’s non-fiction book. Manaugh, repped by Manage-ment and Marc Van Arx, will serve as a consulting producer on the TV project. Nate Miller and Dan Halsted of Manage-ment are also producing, along with Aaron Baiers of Secret Hideout. Alas, I can’t say more about the show at this point, other than to point out that I am absolutely, genuinely over the moon about this, but I am very much looking forward to bringing burglary and architecture to a small screen near you...

If you haven’t checked out the book, meanwhile, consider picking up a copy; many reviews and blurbs can also be found at burglarsguide.com.
 [Images: Via Wired UK]. [Images: Via Wired UK].
Sites of urban infrastructure and other industrial facilities integral to municipal management, from fire stations to fuel depots, appear to be the target of deliberate erasure in Baidu’s street maps.
As photographer Jonathan Browning—who noticed odd moments of incomplete blurring, cloning, and other visual camouflage a few years ago—explains to Wired, “I don't know who does it, if it's an algorithm that gets GPS co-ordinates for each place and then somehow wipes it, or if an actual person goes to each one and cleans it with Photoshop.”
Either way, he adds, “It would be great to meet these people and see what they think about it. If they wanted to do it, why didn’t they do it properly?”
 [Images: Via Wired UK]. [Images: Via Wired UK].
The effects are, in their own way, actually quite interesting, as if some sort of representational glitch has slipped into the world by way of sites of Chinese infrastructure—a scrambling algorithm crawling out of the depths of digital compression to target all these marginal, back-stage spaces that help a 21st-century city operate.
A wildly applied cloning tool in the top set of images for example, actually creates what appear to be reeds, an emergent landscape of the New Aesthetic breaking through the cracks between pixels.
Read more over at Wired UK.
Spotted via @samanthaculp and @larsonchristina).
 [Image: An airplane hangar in Utah, via the U.S. Library of Congress]. [Image: An airplane hangar in Utah, via the U.S. Library of Congress].
Another book I read while jet-lagged in London last week was Skyfaring: A Journey with a Pilot by Mark Vanhoenacker; its chapter “Wayfinding” is particularly fascinating and worth seeking out.
 [Image: Interior view of same hangar, via U.S. Library of Congress]. [Image: Interior view of same hangar, via U.S. Library of Congress].
The previous post here, however, mentioned 19th-century cloud chambers, and I was accordingly struck by a quick line in Vanhoenacker’s book. At one point, he describes the construction of airplane bodies inside sprawling factory buildings, contained volumes of air so enormous they could generate their own weather. They were internal skies.
“Some airplane factories are so large,” he writes, “that clouds once formed inside them, a foreshadowing of the sky to come for each newborn jet.”
 [Image: Utah airplane hangar, via U.S. Library of Congress]. [Image: Utah airplane hangar, via U.S. Library of Congress].
Of course, other megastructures are also known to produce internal precipitation. NASA’s Vehicle Assembly Building at Cape Canaveral “is the second largest building (by volume) in the world,” for example, “and it even has its own weather inside—NASA employees report that rain clouds form below the ceiling on very humid days.”
And, as architecture writers like David Gissen and Sean Lally have compellingly shown, architecture—in and of itself—has, in a sense, always been a kind of applied atmospheric design, with buildings defined as much by temperature, barometry, and humidity as they are by walls and ceilings.
But I nevertheless love the idea of aircraft assembly and repair occurring amidst inadvertent simulations of the sky to come, as dew points are crossed, condensation begins, and internal weather fronts blurrily amass above the wings of dormant airplanes, as if conjured there in a dream.
 [Images: Via Peter Moore’s piece on “dueling weathermen” over at Nautilus]. [Images: Via Peter Moore’s piece on “dueling weathermen” over at Nautilus].
As mentioned in the previous post, I recently had the pleasure of reading Peter Moore’s new book, The Weather Experiment. There are many interesting things in it—including the London “ time ball,” of course—but one scene in particular stood out for its odd design details.
In 19th-century Philadelphia, Moore explains, climate scientist James Espy began building a miniature model of the earth’s atmosphere in his back garden on Chestnut Street. This microcosm was a nephelescope, or “an air pump attached to a barometer and a tubular vessel—something of an early cloud chamber.”
Espy’s larger goal here was to understand the sky as a complexly marbled world of colliding fronts and rising air columns, “an entire dynamic weather system” that could perhaps best be studied through replication.
The sky, that is, could be modeled—and, if correctly modeled, predicted. It was just a question of understanding the physics of “ascending currents of warm air drawing up vapor, the vapor condensing at a specific height, expanding and forming clouds, and then the water droplets falling back to earth.” Under different atmospheric conditions, Espy realized, this system of vaporous circulation was capable of producing every type of precipitation: rain, snow, or hail. His task then became to calculate specific circumstances. What temperature was needed to produce snow? What expansion of water vapor would produce would be required to generate a twenty-mile-wide hailstorm? Why not construct a smaller version of this in your own backyard and watch it go? A garden for modeling the sky.
I love this next bit: “To work with maximum speed,” Moore writes, “he had painted his fence white, so he could use it like an enormous notebook.” The entire fence was soon “covered with figures and calculations,” Espy’s niece recalled, till “not a spot remained for another sum or calculation.”
Espy’s outdoor whiteboard, wrapped around a “space transformed into an atmospheric laboratory, filled with vessels of water, numerous thermometers and hygrometers,” in Moore’s words, would make an interesting sight today, resembling something so much as a set designed for an avant-garde theatrical troupe or a student project at the Bartlett School of Architecture.
Indeed, Espy’s lost sky-math garden suggests some interesting spatial possibilities for a sort of outdoor scientific park, a piece of urban land replicating the atmosphere through both instruments and equations.
 [Image: The London “time ball” at Greenwich, courtesy Royal Museums Greenwich]. [Image: The London “time ball” at Greenwich, courtesy Royal Museums Greenwich].
Thanks to the effects of jet lag getting worse as I get older, I was basically awake for five days in London last week—but, on the bright side, it meant I got to read a ton of books.
Amongst them was an interesting new look at the history of weather science and atmospheric forecasting—sky futures!—by Peter Moore called The Weather Experiment. There were at least two things in it worth commenting on, one of which I’ll save for the next post.
This will doubtless already be common knowledge for many people, of course, but I was thrilled to learn about something called the London “ time ball.” Installed at the Greenwich Royal Observatory in 1833 by John Pond, England’s Royal Astronomer, the time ball was a kind of secular church bell, an acoustic spacetime signal for ships.
It was “a large metal ball,” Moore writes, “attached to a pole at the Royal Observatory. At 1 p.m. each day it dropped to earth with an echoing thud so that ships in the Thames could calibrate their chronometers.” As such, it soon “became a familiar part of the Greenwich soundscape,” an Enlightenment variation on the Bow Bells. Born within sound of the time signal...
 [Image: Historic shot of the time ball, via the South London Branch of the British Horological Institute]. [Image: Historic shot of the time ball, via the South London Branch of the British Horological Institute].
There are many things I love about this, but one is the sheer fact that time was synchronized by something as unapologetically blunt as a sound reverberating over the waters. It would have passed through all manner of atmospheric conditions—through fog and smoke, through rain and wind—as well as through a labyrinth of physical obstructions, amidst overlapping ships and buildings, as if shattering the present moment into an echo chamber.
Calculating against these distortions would have presented a fascinating sort of acoustic relativity, as captains and their crew members would have needed to determine exactly how much time had been lost between the percussive thudding of the signal and their inevitably delayed hearing of it.
In fact, this suggests an interesting future design project: time-signal reflection landscapes for the Thames, or time-reflection surfaces and other acoustic follies for maritime London, helping mitigate against adverse atmospheric effects on antique devices of synchronization.
In any case, the other thing I love here is the abstract idea that, at this zero point for geography—that is, the prime meridian of the modern world—a perfect Platonic solid would knock out a moment of synchrony, and that Moore’s “ echoing thud” at this precise dividing line between East and West would thus be encoded into the navigational plans of captains sailing out around the curvature of the earth, their expeditions grounded in time by this mark of sonic punctuation.
 [Image: “St. Mark's Place, with campanile, Venice, Italy,” via the Library of Congress].
[Image: “St. Mark's Place, with campanile, Venice, Italy,” via the Library of Congress].
Following a number of recent events for A Burglar’s Guide to the City—discussing, among other things, the often less than clear legal lines between interiors and exteriors, between public space and private—I’ve been asked about the Jewish practice of the eruv.
An eruv, in very broad strokes, is a clearly defined space outside the walls of the private home, often marked by something as thin as a wire, inside of which observant Jews are permitted to carry certain items on Shabbat, a day on which carrying objects is otherwise normally prohibited.
As Chabad describes the eruv, “Practically, it is forbidden to carry something, such as a tallit bag or a prayer book from one’s home along the street and to a synagogue or to push a baby carriage from home to a synagogue, or to another home, on Shabbat.”
However, “It became obvious even in ancient times, that on Shabbat, as on other days, there are certain things people wish to carry. People also want to get together with their friends after synagogue and take things with them—including their babies. They want to get together to learn, to socialize and to be a community.”
While, today, “it is an obvious impracticality to build walls throughout portions of cities, crossing over or through streets and walkways, in order to place one's home and synagogue within the same ‘private’ domain,” you can instead institute an eruv: staking out a kind of shared private space, or a public “interior,” as it were. The eruv, Chabad continues, is “a technical enclosure which surrounds both private and hitherto public domains,” and it “is usually large enough to include entire neighborhoods with homes, apartments and synagogues, making it possible to carry on Shabbat, since one is never leaving one's domain.”
In fact, the space of the eruv can absorb truly huge amounts of an existing city, despite the fact that many people will not even know it exists, let alone that they have crossed over into it, that they are “inside” something.
So the question I’ve been posed—although I will defer to more learned colleagues for an informed and accurate answer—is: what does the eruv do to concepts of burglary, if everything taking place inside it, even if technically “outside,” is considered an interior private space? In other words, can any crime committed inside an eruv be considered an act of burglary?
These questions reminded me, in fact, of a commenter named Federico Sanna, who recently pointed out here on the blog that the city of Venice has instituted a new regime for public space in the city by recognizing the entirety of Venice as an eruv.
Writing this with the messy help of Google Translate, the Venetian mayor has signed a law “attesting that the entire city can be considered as one large ‘house,’” or eruv, extending domesticity to the entire metropolis. This eruv will exist for five years, after which, presumably, it will be renewed.
As Sanna points out in his comment, “It must be said: Venice is the place that invented the Ghetto. And this is the 500th anniversary of that event. Venice is the first city to ever constrain Jews in one tiny portion of its urban space–another act that generated architecture, making buildings grow higher and higher to accomodate the growing Jewish population. It is significant, then, if not altogether timely, that it’s Venice that makes this symbolic move of inclusiveness for the first time.”
What effect—if any—this might have on the legal recognition of burglary remains, for me, an interesting question.
 [Image: Undersea augmented reality headgear; courtesy of the U.S. Navy]. [Image: Undersea augmented reality headgear; courtesy of the U.S. Navy].
By now you’ve no doubt seen Hyper-Reality, the new short film produced by visualization wunderkind Keiichi Matsuda, whose early video experiments, produced while still a student at the Bartlett School of Architecture, I posted about here a long while back.
As you can see in the embedded video, above, Matsuda’s film is a POV exploration of information overload, identity gamification, and the mass burial of public space beneath impenetrable curtains of privately relevant, interactive marketing data, all cranked up to the level of cacophony; when it all shuts off at one point, leaving viewers stranded in a nearly silent, everyday supermarket, the effect is almost therapeutic, an intensely relieving escape back to cognition free from popup ads.
 [Image: From Hyper-Reality by Keiichi Matsuda]. [Image: From Hyper-Reality by Keiichi Matsuda].
I thought of Matsuda’s film, however, in the context of the recent news that so-called heads-up displays, or HUDs, are coming to an underwater experience near you: the U.S. Navy has developed an augmented reality helmet for undersea missions. This unique system enables divers to have real-time visual display of everything from sector sonar (real-time topside view of the diver’s location and dive site), text messages, diagrams, photographs and even augmented reality videos. Having real-time operational data enables them to be more effective and safe in their missions—providing expanded situational awareness and increased accuracy in navigating to a target such as a ship, downed aircraft, or other objects of interest. Wandering among enemy seamounts, swimming through immersive 3-dimensional visualizations of currents and tides, watching instructional videos for how to infiltrate an adversary’s port defenses, the U.S. Navy attack crews of the near-future will be like characters in an aquatic Hyper-Reality, negotiating drop-down menus and the threat of moray eels simultaneously.
 [Image: From Hyper-Reality by Keiichi Matsuda]. [Image: From Hyper-Reality by Keiichi Matsuda].
This raises the question of how future landscape architects, given undersea terrains as a possible target of design, might use augmented reality on the seabed.
Recall the preservation program underway today in the Baltic Sea, whereby historically valuable shipwrecks are being given interpretive signage to remind people—that is, possible looters—that what they are seeing down there is not mere debris. They are, in effect, swimming amidst an open-water museum, a gallery of the lost and sunken.
So here’s to someone visualizing the augmented reality underwater shipwreck museum of tomorrow, narratives of immersive data gone oceanic.
 [Image: From L.A. Recalculated by Smout Allen and BLDGBLOG]. [Image: From L.A. Recalculated by Smout Allen and BLDGBLOG].
London-based architects Smout Allen and I have a project in the new issue of MAS Context, work originally commissioned for the 2015 Chicago Architecture Biennial and closely related to our project, L.A.T.B.D., at the University of Southern California Libraries.
Called L.A. Recalculated, the project looks at Greater Los Angeles as a seismically active and heavily urbanized terrain punctuated by large-scale scientific instrumentation, from geophysics to astronomy. This is explained in more detail, below.
Between the drawings and the text, it’s something I’ve been very enthusiastic about for the past year or so, and I’m thrilled to finally see it published. I thus thought I’d include it here on the blog; a slightly edited version of the project as seen on MAS Context appears below. L.A. Recalculated
Commissioned for the 2015 Chicago Architecture Biennial
Los Angeles is a city where natural history, aerospace research, astronomical observation, and the planetary sciences hold outsized urban influence. From the risk of catastrophic earthquakes to the region’s still operational oil fields, from its long history of military aviation to its complex relationship with migratory wildlife, Los Angeles is not just a twenty-first-century megacity.
Its ecological fragility combined with an unsettling lack of terrestrial stability mean that Los Angeles requires continual monitoring and study: from its buried creeks to its mountain summits, L.A. has been ornamented with scientific equipment, crowned with electromagnetic antennae, and ringed with seismic stations, transforming Los Angeles into an urban-scale research facility, a living device inhabited by millions of people on the continent’s westernmost edge.
 [Image: Models from the related project, L.A.T.B.D., by Smout Allen and BLDGBLOG; photo courtesy Stonehouse Photographic].
L.A. Recalculated [Image: Models from the related project, L.A.T.B.D., by Smout Allen and BLDGBLOG; photo courtesy Stonehouse Photographic].
L.A. Recalculated can be seen as a distributed cartographic drawing—part map, part plan, part section—that takes conceptual inspiration from the book OneFiveFour by Lebbeus Woods. There, Woods describes a hypothetical city shaped by the existential threat of mysterious seismic events surging through the ground below. In order to understand how this unstable ground might undermine the metropolis, the city has augmented itself on nearly every surface with “oscilloscopes, refractors, seismometers, interferometers, and other, as yet unknown instruments,” he writes, “measuring light, movement, force, change.”
In this city of instruments—this city as instrument—“tools for extending perceptivity to all scales of nature are built spontaneously, playfully, experimentally, continuously modified in home laboratories, in laboratories that are homes,” exploring the moving surface of an Earth in flux. Architecture becomes a means for giving shape to these existential investigations.
Twenty-first-century Los Angeles has inadvertently fulfilled Woods’s speculative vision. It is less a city, in some ways, than it is a matrix of seismic equipment and geological survey tools used for locating, mapping, and mitigating the effects of tectonic faults. This permanent flux and lack of anchorage means that studying Los Angeles is more bathymetric, we suggest, than it is terrestrial; it is oceanic rather than grounded.
 [Image: Models from the related project, L.A.T.B.D., by Smout Allen and BLDGBLOG; photo courtesy Stonehouse Photographic]. [Image: Models from the related project, L.A.T.B.D., by Smout Allen and BLDGBLOG; photo courtesy Stonehouse Photographic].
L.A. is also a graveyard of dead rocket yards and remnant physics experiments that once measured and established the speed of light using prisms, mirrors, and interferometers in the San Gabriel Mountains (an experiment now marked by historic plaques and concrete obelisks). Further, Los Angeles hosts both the Griffith and Mt. Wilson Observatories through which the region achieved an often overlooked but vital role in the history of global astronomy.
Seen through the lens of this expanded context, Los Angeles becomes an archipelago of scientific instruments often realized at the scale of urban infrastructure: densely inhabited, with one eye on the stars, sliding out of alignment with itself, and jostled from below with seismic tides.
 [Image: From L.A. Recalculated by Smout Allen and BLDGBLOG].
—ONE— [Image: From L.A. Recalculated by Smout Allen and BLDGBLOG].
—ONE—
The surface of Los Angeles is both active and porous. A constant upwelling of liquid hydrocarbons and methane gas is everywhere met with technologies of capture, mitigation, and control. In our proposal, wheeled seismic creepmeters measure the movement of the Earth as part of an experimental lab monitoring potentially hazardous leaks of oil and tar underground.
 [Image: From L.A. Recalculated by Smout Allen and BLDGBLOG].
—TWO— [Image: From L.A. Recalculated by Smout Allen and BLDGBLOG].
—TWO—
The speed of light was accurately measured for the first time just outside this city of sunshine and cinema. Using complex scientific instrumentation assembled from rotating hexagonal prisms, mirrors, and pulses of light, housed inside small, architecturally insignificant shacks in the mountains behind Los Angeles, one of the fundamental constants of the universe was cracked.
 [Image: From L.A. Recalculated by Smout Allen and BLDGBLOG].
—THREE— [Image: From L.A. Recalculated by Smout Allen and BLDGBLOG].
—THREE—
In the heart of the city, atop the old neighborhoods of Chavez Ravine, erased to make way for Dodger Stadium, we propose a series of 360º planetariums to be built. These spherical projections not only reconnect Los Angeles with the stars, constellations, and distant galaxies turning through a firmament its residents can now rarely see; they also allow simulated glimpses into the Earth’s interior, where the planet’s constantly rearranging tectonic plates promise a new landscape to come, a deeper world always in formation. The destroyed houses and streets of this lost neighborhood also reappear in the planetarium shows as a horizon line to remind visitors of the city’s recent past and possible future.
 [Image: From L.A. Recalculated by Smout Allen and BLDGBLOG].
—FOUR— [Image: From L.A. Recalculated by Smout Allen and BLDGBLOG].
—FOUR—
As the city changes—its demography variable, its landscape forever on the move—so, too, do the constellations high above. These shifting heavens allow for an always-new celestial backdrop to take hold and influence the city. A complex architectural zodiac is developed to give a new narrative context for these emerging astral patterns.
 [Image: From L.A. Recalculated by Smout Allen and BLDGBLOG].
—FIVE— [Image: From L.A. Recalculated by Smout Allen and BLDGBLOG].
—FIVE—
Seismic counterweights have long been used to help stabilize skyscrapers in earthquake zones. Usually found at the tops of towers, these dead weights sway back and forth during temblors like vast and silent bells. Here, a field of subterranean pendulums has been affixed beneath the city to sway—and counter-sway—with every quake, a kind of seismic anti-doomsday clock protecting the city from destruction.
 [Image: From L.A. Recalculated by Smout Allen and BLDGBLOG].
—SIX— [Image: From L.A. Recalculated by Smout Allen and BLDGBLOG].
—SIX—
All of the oil, tar, and liquid asphalt seeping up through the surface of the city can be captured. In this image, slow fountains attuned to these percolating ground fluids gather and mix the deeper chemistry of Los Angeles in special pools and reservoirs.
 [Image: From L.A. Recalculated by Smout Allen and BLDGBLOG].
—SEVEN— [Image: From L.A. Recalculated by Smout Allen and BLDGBLOG].
—SEVEN—
The endless jostling of the city, whether due to tectonic activity or to L.A.’s relentless cycles of demolition and construction, can be tapped as a new source of renewable energy. Vast flywheels convert seismic disturbance into future power, spinning beneath generation facilities built throughout the city’s sprawl. Los Angeles will draw power from the terrestrial events that once threatened it.
 [Image: From L.A. Recalculated by Smout Allen and BLDGBLOG].
—EIGHT— [Image: From L.A. Recalculated by Smout Allen and BLDGBLOG].
—EIGHT—
Through sites such as Griffith Observatory and the telescopes of Mt. Wilson, the history of Los Angeles is intimately connected to the rise of modern astronomy. The city’s widely maligned landscape of freeways and parking lots has been reinvigorated through the precise installation of gates, frames, and other architectural horizon lines, aligning the city with solstices, stars, and future constellations. • • •
L.A. Recalculated was commissioned by the 2015 Chicago Architecture Biennial, with additional support from the USC Libraries Discovery Fellowship, the Bartlett School of Architecture, UCL, and the British Council. Special thanks to Sandra Youkhana, Harry Grocott, and Doug Miller.
Meanwhile, check out the closely related project, L.A.T.B.D.. Broadly speaking, L.A.T.B.D. consists of—among many other elements, including narrative fiction and elements of game design—3D models of the architectural scenarios described by L.A. Recalculated.
 [Image: Close-up of the 2010 State Geologic Map of California]. [Image: Close-up of the 2010 State Geologic Map of California].
An interesting story published last month in the L.A. Times explored the so-called “sweet spot” for digging tunnels along the California/Mexico border.
“Go too far west,” reporter Jason Song explained, “and the ground will be sandy and potentially soggy from the water of the Pacific Ocean. That could lead to flooding, which wouldn’t be good for the drug business. Too far east and you’ll hit a dead end of hard mountain rock.”
However, Song continues, “in a strip of land that runs between roughly the Tijuana airport and the Otay Mesa neighborhood in San Diego, there’s a sweet spot of sandstone and volcanic ash that isn’t as damp as the oceanic earth and not as unyielding as stone.”
More accurately speaking, then, it is less a sweet spot than it is a soft one, a location of potential porosity where two nations await subterranean connection. It is all a question of geology, in other words—or the drug tunnel as landscape design operation.
 [Image: Nogales/Nogales, via Google Maps]. [Image: Nogales/Nogales, via Google Maps].
With the very obvious caveat that this next article is set along the Arizona/Mexico border, and not in the San Diego neighborhood of Otay Mesa, it is nonetheless worth drawing attention back to an interesting article by Adam Higginbotham, written in 2012 for Bloomberg, called “ The Narco Tunnels of Nogales.”
There, Higginbotham describes a world of abandoned hotel rooms in Mexico linked, by tunnel, to parking spots in the United States; of streets subsiding into otherwise unknown narco-excavations running beneath; and of an entire apartment building on the U.S. side of the border whose strategic value is only revealed later once drug tunnels begin to converge in the ground beneath it.
Here, too, though, Higginbotham also refers to “a peculiar alignment of geography and geology,” noting that the ground conditions themselves are particularly amenable to the production of cross-border subterranea.
However, the article also suggests that “the shared infrastructure of a city”—that is, Nogales, Arizona, and its international counterpart, Nogales, Mexico—already, in a sense, implies this sort of otherwise illicit connectivity. It is literally built into the fabric of each metropolis: When the monsoons begin each summer, the rain that falls on Mexico is funneled downhill, gathering speed and force as it reaches the U.S. In the 1930s, in an attempt to control the torrent of water, U.S. engineers converted the natural arroyos in Nogales into a pair of culverts that now lie beneath two of the city’s main downtown streets, Morley Avenue and Grand Avenue. Beginning in Mexico, and running beneath the border before emerging a mile into the U.S., the huge tunnels—large enough to drive a car through—created an underground link between the two cities, and access to a network of subterranean passages beneath both that has never been fully mapped. This rhizomatic tangle of pipes, tubes, and tunnels—only some of which are official parts of the region’s hydrological infrastructure—results in surreal events of opportunistic spelunking whereby “kids would materialize suddenly from the drainage grates,” or “you would see a sewer plate come up in the middle of the street, and five people would come up and run.”
Briefly, I’m reminded of a great anecdote from Jon Calame’s and Esther Charlesworth’s book Divided Cities, where the split metropolis of Nicosia, Cyprus, is revealed to be connected from below, served by a shared sewage plant “where all the sewage from both sides of the city is treated.” The authors interview the a local waste manager, who jokes that “the city is divided above ground but unified below.”
In any case, the full article is worth a read, but a tactical geological map revealing sites of likely future tunneling would be a genuinely fascinating artifact to see. I have to assume that ICE or Homeland Security— let alone the cartels—already have such a thing.
(L.A. Times article originally spotted via Nate Berg).
 [Image: From United States of America, Plaintiff v. State of California,” December 15, 2014]. [Image: From United States of America, Plaintiff v. State of California,” December 15, 2014].
This is old, old, old news, widely covered elsewhere at the time, but I rediscovered this link saved in my bookmarks and wanted to post it: back in December 2014, the U.S. Supreme Court redefined the maritime border of California with an amazing, 108+ page sequence of numerical locations in space.
It is geodetic code for marking the western edge of state power—or Sol Lewitt’s instructional drawings given the power of sovereign enforceability.
Rather than “ The Location of a Trapezoid,” in other words, as Lewitt’s work once explored, this is the location of California.
 [Image: From United States of America, Plaintiff v. State of California,” December 15, 2014]. [Image: From United States of America, Plaintiff v. State of California,” December 15, 2014].
Beyond these mathematically exact limits is not the open ocean, however, but sea controlled by the United States federal government. The coordinates laboriously, hilariously reproduced over dozens and dozens of pages simply define where California's “ Submerged Lands” end, or expanses of seafloor where California has the right to explore for economic resources. Outside those submerged lands, the feds rule.
In a sense, then, this is the Supreme Court seemingly trolling California, tying up the Golden State’s perceived western destiny within a labyrinth of constricting arcs and lines, then claiming everything that lies beyond them.
 [Image: The former Polish National Alliance Building, now Studio Gang; via Studio Gang]. [Image: The former Polish National Alliance Building, now Studio Gang; via Studio Gang].
Just a quick reminder that, if you’re in Chicago this Friday, May 27th, Iker Gil, editor-in-chief of MAS Context, and I will be discussing A Burglar’s Guide to the City. We’ll be in the brand new event space inside Studio Gang’s newly renovated offices, the former Polish National Alliance Building on Division Street. The event is co-sponsored by the Seminary Co-Op bookstore, who will also be selling copies of the book. Issues of MAS Context will also be sale.
Stop by to learn about super-tools of architectural breaking & entering, from lock picks to burning bars, about abstract geometric shapes visible only to lawyers enclosing domestic space against the threat of burglary, and about the most prolific bank-robbing crew of the 19th-century—led by a man who trained as an architect—among many other points of discussion.
Things kick off at 6pm, at 1520 W. Division Street. Hope to see you there!
 [Image: Drone footage of a Cornwall garden sinkhole, via the BBC].
[Don’t forget to update your bookmarks to bldgblog.com]. [Image: Drone footage of a Cornwall garden sinkhole, via the BBC].
[Don’t forget to update your bookmarks to bldgblog.com].
One of the peculiar pleasures of reading Subterranea, a magazine published by Subterranea Britannica, is catching up on British sinkhole news.
In more or less every issue, there will be tales of such things as “a mysterious collapse in a garden behind a 19th-century house,” that turns out to be a shaft leading down into a forgotten sand mine, or of “abandoned chalk mine sites” heavily eroding in winter rain storms, “resulting in roof-falls.”
“As most chalk mines are at relatively shallow depth,” Subterranea reports, “these roof-falls migrate upwards to break [the] surface as ‘crown holes’ or craters, which in the said winter [of 2013/2014] have been appearing in lawns and driveways, and even under houses, newly built in chalk districts.”
The earth deceptively hollow, the landscape around you actually a ceiling for spaces beneath.
Worryingly, many of these mines and underground quarries are difficult, if not impossible, to locate, as insufficient regulation combined with shabby documentation practices mean that there could be abandoned underground workings you might never be aware of hiding beneath your own property—until next winter’s rains kick in, that is, or the next, when you can look forward to staring out at the grass and shrubbery, with growing angst, waiting for sinkholes to appear. Rain becomes a kind of cave-finding technology.
Even in the heart of London, the underworld beckons. Last Spring, Subterranea reminds us, “a woman and her shopping trolley rather suddenly disappeared into a four metres deep hole in North End Road, Fulham.” The culprit? It “appears to have been a disused under-street coal cellar.”
Perhaps the most incredible recent example, however, comes from the town of Scorrier, in Cornwall.
 [Image: Photo courtesy The Sun]. [Image: Photo courtesy The Sun].
There, a “deep mine shaft has appeared” beneath the patio of a house in the process of being prepped for sale. “The shaft drops approximately 300 feet deep to water but could be four or five times deeper [!] below that,” Subterranea reports. It “is a remnant of Cornwall’s tin mining industry in the 18th century.”
It is a straight vertical shaft, more like a rectangular well, yawning open behind the house.
And there are many more of these mines and quarries, still waiting to be discovered: “As mines closed,” we read, “many [mining companies] put very large blocks of timber, often old railway sleepers, across shafts and backfilled them, thinking this would be safe. Gradually all evidence of the engine houses and covered shafts disappeared from view and memory and in the past builders assumed there was nothing there. Had they consulted old maps they would have known about the shaft. The timbers rotted over the years and collapses like this often happen after long periods of rain, which they have had in this area.”
There’s something both uncanny and compelling about the idea that, with seasons of increased rainfall due to climate change, the nation’s mining industry might stage an unsettling reappearance, bursting open in subterranean splendor to swallow the surface world whole.
Think of it as an industrial-historical variation on the El Niño rains in Los Angeles—where huge storms were suspected of “unearthing more skeletal human remains” in the parched hills outside the city—only here given the horror movie ambience of murderous voids opening up beneath houses, making their abyssal presence felt after long winter nights of darkness and endless rain.
In any case, consider joining Subterranea Britannica for a subscription to Subterranea for more sinkhole news.
 [Image: An otherwise unrelated photo of a “Scout” UAV, via Wikipedia].
[Don’t forget to update your bookmarks to bldgblog.com]. [Image: An otherwise unrelated photo of a “Scout” UAV, via Wikipedia].
[Don’t forget to update your bookmarks to bldgblog.com].
There’s an interesting short piece by Jacob Hambling in a recent issue of New Scientist about the use of “ persistent drones” to “hold territory in war zones,” effectively sealing those regions off from incursion. It is an ominous vision of what we might call automated quarantine, or a cordon it’s nearly impossible to trespass, maintained by self-charging machines.
Pointing out the limitations of traditional air power and the tactical, as well as political, difficulties in getting “boots on the ground” in conflict zones, Hambling suggests that military powers might turn to the use of “persistent drones” that “could sit on buildings or trees and keep watch indefinitely.” Doing so “expands the potential for intervention without foot soldiers,” he adds, “but it may lessen the inhibitions that can stop military action.”
Indeed, it’s relatively easy to imagine a near-future scenario in which a sovereign or sub-sovereign power—a networked insurgent force—could attempt to claim territory using Hambling’s “persistent drones,” as if playing Go with fully armed, semi-autonomous machines. They rid the land of its human inhabitants—then watch and wait.
Whole neighborhoods of cities, disputed terrains on the borders of existing nations, National Wildlife Refuges—almost as an afterthought, in a kind of political terraforming, you could simply send in a cloud of machine-sentinels to clear and hold ground until the day, assuming it ever comes, that your actual human forces can arrive.
A friendly reminder that, if you can read this post, you should update your RSS feed for the new BLDGBLOG:
http://www.bldgblog.com/feed/
As well as any existing links you might have for the site. Stop by bldgblog.com for more...
 [Image: Flying with the LAPD; photo by BLDGBLOG]. [Image: Flying with the LAPD; photo by BLDGBLOG].
Just a quick heads up about three more Burglar’s Guide-related events coming up this month:
Monday, May 9th, AIA Center for Architecture, New York City—I’ll be speaking with fellow crime-enthusiast Tom Vanderbilt about various themes explored in the book, from lock picking and police helicopter flights over Los Angeles to security vulnerabilities hidden in a city’s fire code. Vanderbilt himself has a new book of his own out next week, called You May Also Like: Taste in an Age of Endless Choice, and he is also the author of Traffic and Survival City. Things kick off at 6pm. RSVP at the Center for Architecture. Books will be available for purchase courtesy of Brooklyn’s Greenlight Bookstore.
Wednesday, May 18th, National Building Museum, Washington D.C.—Stop by the National Building Museum to watch clips from heist films, and to discuss the art of the getaway route, a typology of burglar's tools, and much more. I’ll be introducing films, from Rififi to The Day They Robbed The Bank Of England, and speaking with Ross Andersen, senior editor of The Atlantic, for a full evening of crime and the city. Things begin at 6:30pm. Pick up a ticket from the National Building Museum website.
Friday, May 27th, Studio Gang, Chicago—Iker Gil, editor-in-chief of MAS Context, will be moderating a lively conversation about A Burglar’s Guide to the City in the newly renovated office space of Jeanne Gang’s Chicago architecture firm, Studio Gang, winner of the 2016 Architect of the Year Award from The Architectural Review. Even better? It’s in a converted bank. Books will be for sale courtesy of the Seminary Co-op Bookstore.
Stop by any (or all!) if you’re nearby, and be sure to say hello.

The west coast leg of the book tour for A Burglar’s Guide to the City is coming to an end. I wanted to give readers near Portland and Seattle a quick heads up about events in those cities this week, in case you might be looking for something to do.
Stop by Powell’s tomorrow night—Tuesday, the 3rd, at 7:30—or Town Hall Seattle on Thursday night, May 5th, also at 7:30, to pick up a signed copy and to hear some stories from the book, from an unsolved subterranean bank heist in 1980s Los Angeles to the design war going on between the tools of breaking & entering and architectural fortification.
If you’re on the fence about reading the thing, meanwhile, check out Alex Bozikovic’s great review for The Globe and Mail. Bozikovic thinks A Burglar’s Guide to the City “gives the realm of architecture the kinetic thrills of a heist film.”
Alternatively, Marc Weingarten of The Guardian has an enthusiastic look at the book, as well. He writes that the Burglar’s Guide “locates the spot where architecture and crime intersect. It’s the dark side of urbanist Jane Jacobs’s 1961 work The Death and Life of Great American Cities, depicting the city and its environs as incubator for uncivil activity.”
The Atlantic’s CityLab has also discussed the book, as has Boing Boing, in a fantastic review by Cory Doctorow.Many more media links can also be found either here on BLDGBLOG or over at burglarsguide.com.
Of course, I know it’s not hugely compelling to hear an author touting a new book over and over again! It’s like sitting through an infomercial you didn’t intend to tune to. But I’m not only thrilled the book is finally out there, after having worked on it for the past three years; I’d also love to say hello to any BLDGBLOG readers who might be out there while I'm on the road.
A few more events—in New York City, Chicago, and D.C.—are also coming up, but I'll post about those as they draw near.
 [Image: From Financial Growth by Heidi Hinder; photo by Jonathan Rowley]. [Image: From Financial Growth by Heidi Hinder; photo by Jonathan Rowley].
I somewhat randomly found myself reading back through the irregularly updated blog of the British Museum earlier today when I learned about a project by Bristol-based artist Heidi Hinder called Financial Growth.
Financial Growth, Hinder explains in her guest post for the blog, is a still-ongoing “series of petri dish experiments.” It “reveals the bacteria present on coins and suggests that each time we make a cash transaction, we are exchanging more than just the monetary value and some tangible tokens. Hard currency could become a point of contagion.”
 [Image: From Financial Growth by Heidi Hinder; photo by Jonathan Rowley]. [Image: From Financial Growth by Heidi Hinder; photo by Jonathan Rowley].
While Hinder develops this train of thought into a lengthy and provocative look at other means by which human beings could exchange microbes and bacteria for the purposes of financial interaction, I was actually unable to go much beyond than sheer awe at the basic premise of the project.
 [Image: From Financial Growth by Heidi Hinder; photo by Jonathan Rowley]. [Image: From Financial Growth by Heidi Hinder; photo by Jonathan Rowley].
By culturing individual coins, Hinder has revealed a vibrant ecosystem of microscopic lifeforms thriving, garden-like, on every monetary token in our pockets; these are landscapes-in-waiting that we carry around with us every day.
 [Image: From Financial Growth by Heidi Hinder; photo by Jonathan Rowley]. [Image: From Financial Growth by Heidi Hinder; photo by Jonathan Rowley].
I was reminded of the famous shot of “the bacteria that grew when an 8-year-old boy who had been playing outside pressed his hand onto a large Petri dish,” posted to Microbe World last autumn.
 [Image: Via Microbe World]. [Image: Via Microbe World].
We’re surrounded by the unexpected side-effects of these portable microbial communities.
We leave our traces everywhere—but we bear the traces of innumerable others, in turn, trafficking amongst microbiomes that are content to remain invisible until we force them to reveal themselves.
 [Image: Via Microbe World]. [Image: Via Microbe World].
Think of artist Maria Thereza Alves’s project, Seeds of Change, for example, a “ ballast seed garden” that explored the hidden landscapes unwittingly carried along by ships of European maritime trade, with seeds unceremoniously dumped as part of their ballast, often centuries old.
 [Image: Maria Thereza Alves's Seeds of Change garden, via Facebook]. [Image: Maria Thereza Alves's Seeds of Change garden, via Facebook].
These were seeds left behind specifically from the ballast of ships—yet isn’t that exactly what Hinder’s project also explores, the portable, everyday ballast of bacteria left behind on our cash, our coins, our hands, our bodies?
After all, 94% of the money we handle every day has human feces on it. Put it in a petri dish and be wary of what begins to grow.
While Hinder’s larger point is that perhaps we could design a microbe-exchange economy based on the already-existing trade in bacteria we are all currently engaged in, whether we know it or not, the brute-force power of revelation makes Financial Growth grotesquely compelling.
We bring with us nearly infinite potential landscapes, carrying them in our wallets, purses, and pockets—on our hands, in the random waste left behind by ships and even airplanes—forming new, erratic ecosystems, a pop-up micro-wilderness we’re unable to control.
 [Image: Robert Moses, via Wikipedia]. [Image: Robert Moses, via Wikipedia].
I’ve been meaning to post about this since I first heard about it: a competition to design a game based on Robert Caro’s book The Power Broker: Robert Moses and the Fall of New York.
As Tim Hwang of the Infrastructure Observatory writes, “we are launching a competition that challenges game designers to adapt The Power Broker into a playable, interactive form that preserves the flavor and themes of the written work, while leveraging the unique opportunities the game medium provides.” They are “seeking submissions both in a video game category, as well in a separate tabletop game category.”
Although I am obviously already biased toward game-creation as a form of urban analysis, the possibilities here are incredibly interesting. If you missed Gothamist’s great interview with Robert Caro, meanwhile, it’s well worth reading, serving as an engagingly free-wheeling introduction to Caro’s now-classic book, including several damning insights into how Moses abused infrastructural design as a new form of political power.
“Moses came along with his incredible vision,” Caro explains, for example, “and vision not in a good sense. It’s like how he built the bridges too low.” I remember his aide, Sid Shapiro, who I spent a lot of time getting to talk to me, he finally talked to me. And he had this quote that I’ve never forgotten. He said Moses didn’t want poor people, particularly poor people of color, to use Jones Beach, so they had legislation passed forbidding the use of buses on parkways.
Then he had this quote, and I can still [hear] him saying it to me. “Legislation can always be changed. It’s very hard to tear down a bridge once it’s up.” So he built 180 or 170 bridges too low for buses.
We used Jones Beach a lot, because I used to work the night shift for the first couple of years, so I’d sleep til 12 and then we’d go down and spend a lot of afternoons at the beach. It never occurred to me that there weren’t any black people at the beach.
So [my wife] Ina and I went to the main parking lot, that huge 10,000-car lot. We stood there with steno pads, and we had three columns: Whites, Blacks, Others. And I still remember that first column —there were a few Others, and almost no Blacks. The Whites would go on to the next page. I said, God, this is what Robert Moses did. This is how you can shape a metropolis for generations. You have until April 29th to register for the game-design competition; you can find more information on the competition website.
 [Image: Inside Tadao Ando’s studio in Osaka; photo by Kaita Takemura, via designboom].
[Image: Inside Tadao Ando’s studio in Osaka; photo by Kaita Takemura, via designboom].
Somewhere, despite the weather here, it’s spring. If you’re like me, that means you’re looking for something new to read. Here is a selection of books that have crossed my desk over the past few months—though, as always, I have not read every book listed here. I have, however, included only books that have caught my eye or seem particularly well-fit for BLDGBLOG readers due to their focus on questions of landscape, design, architecture, urbanism, and more.
For previous book round-ups, meanwhile, don’t miss the back-links at the bottom of this post.
 1) The Strait Gate: Thresholds and Power in Western History
1) The Strait Gate: Thresholds and Power in Western History by Daniel Jütte (Yale University Press)
Daniel Jütte’s The Strait Gate seems largely to have slipped under the radar, but it’s my pick for the most interesting architectural book of the last year (it came out in 2015). It has a deceptively simple premise. In it, Jütte tells the story of the door in European history: the door’s ritual symbolism, its legal power, its artistic possibilities, even its betrayal through basic crimes such as trespassing and burglary. He calls it “a study of doors, gates, and keys and a history of the hopes and anxieties that Western culture has attached to them”; it is a way of “looking at history through doors.”
Jütte describes locks (and their absence), city walls (and their destruction), marriage (and the literal threshold a newly joined couple must cross), medicinal rituals (connected “with the idea of passing through a doorway”), even the doorway to Hell (and its miraculous sundering). You know you’re reading a good book, I’d suggest, when something pops up on nearly every page that you need to mark with a note for coming back to later or that gives you some unexpected new historical or conceptual detail you want to write about more yourself. An entire seminar could be based on this one book alone.
2) Witches of America by Alex Mar (Farrar, Straus and Giroux)
Witches of America is simultaneously an introduction to alternative religious practices in the United States—specifically, contemporary paganism, broadly understood—and a first-person immersion in those movements and their cultures. As such, the book is a personal narrative of attraction to—but also ongoing frustration with—the world found outside mainstream beliefs or creeds.
As such, it ostensibly falls beyond the pale of BLDGBLOG—yet the book is worth including here for what it reveals about the spatial settings of these new and, for me, surprisingly vibrant communities. There is the abandoned churchyard in New Orleans, for example, now repurposed—and redecorated—by a group of 21st-century acolytes of Aleister Crowley; there is the remote stone circle built in Northern California by what I would describe as a post-hippie couple with access to land-moving equipment; there is the otherwise indistinguishable collegiate house in central Massachusetts where training future “priests” in the shadow of New England’s peculiar history with witch trials; there is the corporate convention center in downtown San Jose; the overgrown tombs of the Mississippi Delta, where we meet a rather extraordinary—and macabre—burglar; there is even what sounds like an Airbnb rental gone unusually haywire in the lake-rich hills of New Hampshire.
While descriptions of these settings are certainly not the subject of Alex Mar’s book, it is nonetheless fascinating to see the world of the esoteric, the otherworldly, or, yes, the occult presented in the context of our own everyday surroundings, with all of their often-mundane dimensions and atmosphere. This alone should make this an interesting read, even for those who might not share the author’s curiosity about the “witches of America.”
3) The Work of the Dead: A Cultural History of Mortal Remains by Thomas W. Laqueur (Princeton University Press)
The Work of the Dead looks at the role not just of death but specifically of dead bodies in shaping our cities, our landscapes, our battlefields, and our imaginations. The question of what to do with the human corpse—how to venerate it, but also how to do dispose of it and how to protect ourselves from its perceived pestilence—has led, and continues to lead, to any number of spatial solutions.
Laqueur writes that “there seems to be a universally shared feeling not only that there is something deeply wrong about not caring for the dead body in some fashion, but also that the uncared-for body, no matter the cultural norms, is unbearable. The corpse demands the attention of the living.”
Graveyards, catacombs, monuments, charnel grounds: these are landscapes designed in response to human mortality, reflective of a culture’s attitude to personal disappearance and emotional loss. While author Thomas Laqueur’s approach is often dry (and long-winded), the book’s thorough framing of its subject lends it an appropriate weight for something as universal as the end of life.
If this topic interests you, meanwhile, I also recommend Necropolis: London and Its Dead by Catharine Arnold (Simon & Schuster), as well as Making an Exit: From the Magnificent to the Macabre—How We Dignify the Dead by Sarah Murray (Picador).
4) The Invention of Nature: Alexander von Humboldt’s New World by Andrea Wulf (Alfred A. Knopf)
Andrea Wulf’s biography of Alexander von Humboldt has justifiably won the author a series of literary awards. Its subject matter is by no means light, yet the book has the feel of an adventure tale, pulling double duty as the life-story of a European scientist and explorer but also as a history of scientific ideas, ranging from the origins of color and the nature of speciation to some of the earliest indications of global atmospheric shifts—that is, of the possibility of climate change.
Natural selection, cosmology, volcanoes—even huge South American lakes full of electric eels—the book is a great reminder of the importance of curiosity and travel, not to mention the value of an inhuman world against which we should regularly measure ourselves (and come out lacking). “In a world where we tend to draw a sharp line between the sciences and the arts, between the subjective and the objective,” Wulf writes, “Humboldt’s insight that we can only truly understand nature by using our imagination makes him a visionary.”
 5) Sounding the Limits of Life: Essays in the Anthropology of Biology and Beyond
5) Sounding the Limits of Life: Essays in the Anthropology of Biology and Beyond by Stefan Helmreich (Princeton University Press)
You might recall seeing Stefan Helmreich’s work described here before—specifically his earlier book, Alien Ocean: Anthropological Voyages in Microbial Seas—but Sounding the Limits of Life is arguably even more relevant to many of the ongoing themes explored here on the blog.
In his new book, Helmreich outlines a kind of acoustic ecology of the oceans, placing deep-sea creatures and shallow reefs alike in a world of immersive sound and ambient noise, now all too often interrupted by the deafening pings of naval sonar. He also uses the seemingly alien environment of the seas, however, to expand the conversation to include speculation about what life might be like elsewhere, using maritime biology as a launching point for discussing SETI, artificial digital lifeforms, Martian fossils (from Martian seas), and much more.
It’s a book about how our “definition of ‘life’ is becoming unfastened from its familiar grounding in earthly organisms,” Helmreich writes, as well as an attempt to explore “what life is, has been, and may yet become—whether that life is simulated, microbial, extraterrestrial, cetacean, anthozoan, planetary, submarine, oceanic, auditory, or otherwise.”
6) Pinpoint: How GPS Is Changing Technology, Culture, and Our Minds by Greg Milner (W.W. Norton)
I had been looking forward to this book, exploring the relationship between mapping and the world, ever since reading an op-ed by the author, Greg Milner, in The New York Times about “ death by GPS.” Milner’s book is specifically about the Global Positioning System and its power over our lives: how GPS shapes our sense of direction and geography, what it has done for navigation on a planetary scale, and even how it has transformed the way we grow our global food supply.
7) The Stack: On Software and Sovereignty by Benjamin Bratton (MIT Press)
Design theorist Benjamin Bratton’s magnum opus is a fever-dream of computational geopolitics, “accidental megastructures,” cloud warfare, predictive mass surveillance, speculative anthropology, digital futurism, infrastructural conspiracy theory—a complete list would be as long as Bratton’s already substantial book, and would also overlap quite well with the utopian/dystopian science fiction it often seems inspired by.
In Bratton’s hands, these abstract topics become, at times, almost incantatory—as if William S. Burroughs had taken a day job with the RAND Corporation. As information technology continues to exhibit geopolitical effects, Bratton writes, “borderlines are rewritten, dashed, curved, erased, automated; algorithms count as continental divides; (...) interfaces upon interfaces accumulate into networks, which accumulate into territories, which accumulate into geoscapes (...); the flat, looping planes of jurisdiction multiply and overlap into towered, interwoven stacks...” He writes of “supercomputational utopias” and the “ambient geopolitics of consumable electrons.”
It’s a mind-bending and utterly unique take on technology’s intersection not only with governance but with the fate of the humanist project.
8) You Belong To The Universe: Buckminster Fuller and the Future by Jonathon Keats (Oxford University Press)
Jonathon Keats’s new book simultaneously attempts to debunk and to clarify some of the cultural myths surrounding Buckminster Fuller, a man who described himself, Keats reminds us, as a “comprehensive anticipatory design scientist.” For fans of Fuller’s work, you’ll find the usual suspects here—his jewel-like geodesic domes, his prescient-if-ungainly Dymaxion homes—but also a chapter about Fuller’s work with and influence on the U.S. military in an age of nuclear war games and “domino theories” overshadowing Vietnam.
 9) Rome Measured and Imagined: Early Modern Maps of the Eternal City
9) Rome Measured and Imagined: Early Modern Maps of the Eternal City by Jessica Maier (University of Chicago Press)
Art historian Jessica Maier’s book suggests that changes in the way the city of Rome was mapped over the centuries simultaneously reveal larger shifts in European cultural understandings of space and geography. Her argument hinges on a sequence of surveys and maps chosen not just for their visual or cartographic power—which is considerable, as the book has many gorgeous reproductions of old engraved city maps, views, and diagrams—but for their influence on later geographic projects to come.
Broadly speaking, the documents Maier discusses are meant to be seen as passing from being artistic, narrative, or abstractly emblematic of the idea of greater “Rome” to a more rigorous, modern approach based in measurement, not mythology.
This widely accepted historical narrative begins to crumble, however, as Maier puts pressure on it, especially through the example of Giovanni Battista Piranesi’s etching of the Campus Martius. This is an image of Rome that “was neither documentary nor reconstructive,” Maier suggests, and that thus had more in common with those earlier, more folkloristic emblems of the city. In today’s vocabulary, we might even describe Piranesi’s Campus Martius as an example of “design fiction.”
10) Till We Have Built Jerusalem: Architects of the New City by Adina Hoffman (Farrar, Straus and Giroux)
This is a remarkable and often beautifully written history of modern Jerusalem, as told from the point of view of its architecture. Jerusalem is a city, author Adina Hoffman writes, that “has a funny way of burying much of what it builds.” It is a place of “burials, erasures, and attempts to mark political turf by means of culturally symbolic architecture and hastily rewritten maps.” The book, she adds, “is an excavation in search of the traces of three Jerusalems and the singular builders who envisioned them.”
Indeed, the book is structured around the lives of three architects. The story of German Jewish designer Erich Mendelsohn—probably most well-known today for his futurist “ Einstein Tower” in Potsdam—looms large, as do the lives of Austen St. Barbe Harrison, “Palestine’s chief government architect,” and the “possibly Greek, possibly Arab” Spyro Houris.
Hoffman’s work is a mix of the archaeological, the biographical, and even the geopolitical, as individual building sites—even specific businesses and kilns—become microcosms of territorial significance, embedded in and misused by nationalistic narratives that continue to reach far beyond the boundaries of the city.
11) City of Demons: Violence, Ritual, and Christian Power in Late Antiquity by Dayna S. Kalleres (University of California Press)
City of Demons looks at three cities—Antioch, Jerusalem, and Milan—in the context of early Christianity, when the streets and back alleys of each metropolis were still lined with temples dedicated to older gods and when alleged opportunities for spiritual corruption seemed to lie around every corner. Historian Dayna Kalleres writes that the cities of late antiquity were all but contaminated with demons: imagined malignant forces that had to be repelled by Christian ritual and belief. Cities, in other words, had to be literally exorcized by a practice of “urban demonology,” driven out of the metropolis by such things as church-building schemes and public processions.
While the book is, of course, an academic history, it is also evocative of something much more literary and thrilling, which is a nearly-forgotten phase of Western urban history when forces of black magic lurked in nearly every doorway and civilians faced security threats not from terrorists but from “the marginal, ambiguous, and protean,” from these hidden demonological influences that the righteous were compelled to expunge.
12) City of Thorns: Nine Lives in the World’s Largest Refugee Camp by Ben Rawlence (Picador)
City of Thorns looks at the Dadaab refugee camp in northern Kenya through various lenses: economic, political, and humanitarian, to be sure, but also ethical and anthropological, even to a certain extent architectural.
While author Ben Rawlence’s goal is not, thankfully, to discuss the camp in terms of its design, he does nevertheless offer a crisp descriptive introduction to life in a sprawling settlement such as this, from its cinemas and police patrols to its health facilities and homes. “Our myths and religions are steeped in the lore of exile,” he writes, “and yet we fail to treat the living examples of that condition as fully human.” The camp, we might say in this context, is the urbanism of exile.
 13) Ghettoside: A True Story of Murder in America
13) Ghettoside: A True Story of Murder in America by Jill Leovy (Spiegel & Grau)
I went through a nearly three-year spate of reading law-enforcement memoirs and books about urban policing while researching my own book, A Burglar’s Guide to the City. The excellent Ghettoside by Jill Leovy came out at the very end of that peculiar literary diet—but it also showed-up the rest of those books quite handily.
Ghettoside is bracing, sympathetic, and emotionally nuanced in its week-by-week portrayal of LAPD homicide detectives investigating the murder of a fellow detective’s teenage son. Much larger than this, however, is Leovy’s dedication throughout the book to sorting through the overlapping mazes of media disinformation that have turned “black-on-black” crime into nothing more than a dismissive explanation of something genuinely horrific, a way to paper-over “ racist interpretations of homicide statistics,” in reviewer Hari Kunzru’s words. More damningly, Ghettoside insists, this ongoing wave of murders and revenge-killings is not some new urban state of nature, but is entirely capable of being stopped.
Indeed, Leovy clearly and soberly shows through years of L.A. homicide reporting that today’s epidemic of violence primarily targeting African-American males is due to a failure of law enforcement—or, in her words, “where the criminal justice system fails to respond vigorously to violent injury and death, homicide becomes endemic.” Yet the answer, she explains, is more policing, not less. As an endorsement of effective, community-centered police work, the book is unparalleled.
No matter what side you think you might be on in the growing—and entirely unnecessary—divide between police and the populace they are hired to serve, this is a superb guide to the complexities of law enforcement in contemporary Los Angeles and, by extension, in every American metropolis.
14) The City That Never Was by Christopher Marcinkoski (Princeton Architectural Press)
Christopher Marcinkoski’s book is a fascinating exploration of the relationships between “volatile fiscal events” and “speculative urbanization,” with a specific focus on a cluster of failed urban projects in Spain. Marcincoski defines speculative urbanization as “the construction of new urban infrastructure or settlement for primarily political or economic purposes, rather than to meet real (as opposed to artificially projected) demographic or market demand.”
Although the author jokes that his book is actually quite late to the conversation—discussing the spatial fallout of a global financial crisis that was already five years old by the time he began writing—it is actually a remarkably timely study, as well as a sad assessment of how easily architectural production can become ensnared in economic forces far more powerful than humanism or design.
15) Slow Manifesto: Lebbeus Woods Blog edited by Clare Jacobson (Princeton Architectural Press)
Lebbeus Woods was both a friend and a personal hero of mine; his blog, which lasted from 2007 to shortly before his death in 2012, has now been collated, edited, and preserved by Princeton Architectural Press, with more than 300 individual entries. While primarily text, the books also includes several black-and-white images, including pages from his otherworldly sketchbooks. Thoughts on “wild buildings,” war, borders, September 11th, the now also deceased designer Zaha Hadid, and Woods’s own intriguing mix of cinematic/fictional and analytic/documentary modes of writing abound.
 16) Almost Nature
16) Almost Nature by Gerco de Ruijter (Timmer Art Books)
I’ve written about Dutch photographer Gerco de Ruijter fairly extensively in the past—most recently in a piece about “ grid corrections”—so I was thrilled to see that some of his aerial work has been collected in a new, beautifully realized edition. It collects photos of stabilized coastlines and tree farms, grids and borders.
“Is the wilderness wild?” an accompanying text by Dirk van Weelden asks. “Cities and industrial farming make it seem man is in perfect control,” van Weelden continues later in the essay. “The reality is far more interesting. (...) The truly uncontrollable forces of nature are mutation, chance, hybridity, and contamination,” all subjects de Ruijter’s photos document at various scales, in every season.
17) Niche Tactics: Generative Relationships Between Architecture and Site by Caroline O’Donnell (Routledge)
In the guise of what looks—and even, to some extent, physically feels—like a textbook there is hidden a fantastic study of how buildings relate to their surroundings.
More precisely, Caroline O’Donnell’s investigation of “architecture and site” hopes to reveal how, during the design process, the context of a building affects that building’s final form. Questions of autonomy (do buildings need to reflect or refer to their settings at all?) and generation (can the essence of a site be “extracted” to give shape to the final building?) are woven through a series of essays about ugliness, architectural history, colonialism, monstrosity, and more.
18) How to Thrive in the Next Economy: Designing Tomorrow’s World Today by John Thackara (Thames & Hudson)
John Thackara is already widely known for his advocacy of “sustainability” in design—a word I deliberately put in scare-quotes because Thackara himself would prefer, I presume, a term more like transformative or even revolutionary design. That is, design that can flip the world on its head, not through violence, but through unexpected and strategic solutions to problems that often remain undiagnosed or overlooked. This new, short book looks at everything from mass transit to internet access, clothing manufacture to desertification, aging to fresh water, seeking nothing less than “a new concept of the world.” “The core value of this emerging economy is stewardship,” he writes, “rather than extraction.”
19) Design and Violence edited by Paola Antonelli and Jamer Hunt (Museum of Modern Art)
This book, crisply designed by Shaz Madani, documents an exhibition and debate series of the same name hosted by the Museum of Modern Art. Presented here as a combination of short essays by various authors—myself included—and provocative design objects, products, and public events, the aim is both to startle and to moderate. That is, the book seeks to bring together conflicting sides of often quite fierce arguments about the role of design, including how design can be used to mitigate or even, on occasion, to perpetuate violence. There are 3D-printed guns and a short history of the AK-47 alongside examples of prison architecture, classified surveillance aircraft, slaughterhouse diagrams, and border walls, to name but a few.
• • •
Briefly noted. Other books that have crossed my desk this season include Pandemic: Tracking Contagions, from Cholera to Ebola and Beyond by Sonia Shah (Farrar, Straus and Giroux), Pirates, Prisoners, and Lepers: Lessons from Life Outside the Law by Paul H. Robinson and Sarah M. Robinson (Potomac Books), Memories of the Moon Age by Lukas Feireiss (Spector Books), Shanshui City by Ma Yansong (Lars Müller Publishers), the double publication of Scaling Infrastructure and Infrastructural Monument from the MIT Center for Advanced Urbanism (Princeton Architectural Press), Living Complex: From Zombie City to the New Communal by Niklas Maak (Hirmer), and Smoke Gets in Your Eyes: And Other Lessons from the Crematory by Caitlin Doughty (W.W. Norton).
Finally, although I have mentioned it many times before, I do also have a new book of my own that just came out last week, called A Burglar’s Guide to the City; if you’d prefer to sample the goods before purchasing, however, you can check out an excerpt in The New York Times Magazine. But please consider supporting BLDGBLOG by ordering a copy—not least because then we can talk about burglary, architecture, and heists...
Thanks!
All Books Received: August 2015, September 2013, December 2012, June 2012, December 2010 (“Climate Futures List”), May 2010, May 2009, and March 2009.
|
|
 [Image: From The Hunt For Red October, via Quora].
[Image: From The Hunt For Red October, via Quora].


































 [Image: From
[Image: From [Image: From
[Image: From [Image: From
[Image: From [Image: From
[Image: From  [Image: Via
[Image: Via [Image: Via
[Image: Via  [Image: Maria Thereza Alves's Seeds of Change garden, via
[Image: Maria Thereza Alves's Seeds of Change garden, via  [Image: Robert Moses, via
[Image: Robert Moses, via  [Image: Inside Tadao Ando’s studio in Osaka; photo by Kaita Takemura, via
[Image: Inside Tadao Ando’s studio in Osaka; photo by Kaita Takemura, via 







